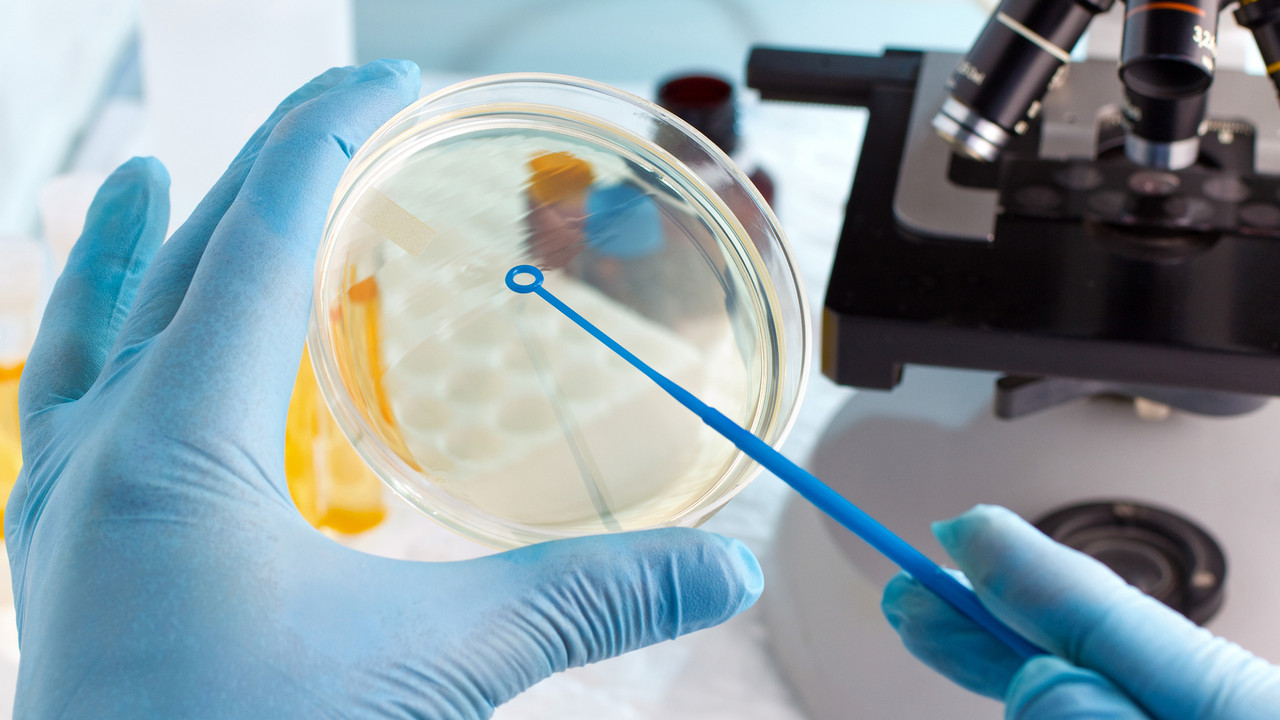

Важные факты о медицинских анализах
- 5 июля 2022
- administrator


Приходилось ли вам когда-нибудь «лечиться в аптеке» - то есть покупать антибиотики не по назначению врача, а по совету фармацевта? Наверняка! А значит, всё, что написано ниже – для вас.
Дело в том, что, приобретая лекарственные препараты, рекомендованные провизором, вы, по сути, стреляете из пушки по воробьям. Ведь врач составляет для пациента целую схему лечения и выбирает препараты не по наитию, а основываясь на результатах персонального обследования и, прежде всего, - медицинских анализов. В этом и только в этом случае можно быть уверенным в эффективности лечения!
ЮНИЛАБ
Факт №1 «Высокие технологии»
Бактериологические анализыЮНИЛАБмасс-спектрометре750
Факт №2 «Уникальность»
ЮНИЛАБЮНИЛАБ
Факт №3 «Гарантия эффективности»
ЮНИЛАБанализы на инфекционные и грибковые заболевания
Факт №4 «Скорость»,
который для многих может оказаться решающим в выборе лаборатории: даже сложные анализы ЮНИЛАБ делает в минимальные сроки. Это происходит потому, что весь биоматериал исследуется здесь же, на месте, а не вывозится в другие регионы, где располагаются, к примеру, лаборатории федеральных клиник. Таким образом, исследования, которые в этих клиниках делают за неделю и больше, в ЮНИЛАБ будут готовы через 4 дня.
А значит, и лечение пациенту будет назначено быстрее, и препараты подобраны верно, и, в результате, эффект наступит вовремя.
ЮНИЛАБhttps://unilab.su/
Имеются противопоказания. Необходима консультация специалиста.